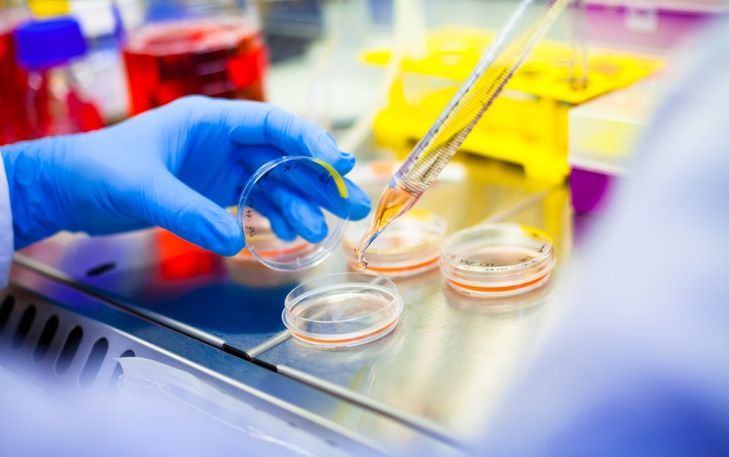
Odoo • Texte et Image

Licence Sciences et Techniques
Génie Biomédicale et Santé
Coordonnateur de la filière
Pr. Fatiha CHIGR
Département : Sciences de la vie
E-mail : f.chigr@usms.ma
Contenu de la formation
Semestre 1
-
Cosmologie & Géodynamique Interne
-
Biologie cellulaire
-
Structure de la Matière
-
Analyse / Algèbre
-
Optique et radioactivité
-
Langues et techniques de communication (Français 1)
-
Méthodologie de travail universitaire
Semestre 2
-
Réactivité chimique
-
Thermodynamique et mécanique des fluides
-
Biologie animale / Biologie végétale
- Bases des données
-
Géodynamique externe
-
Langues et techniques de communication (Anglais 1)
-
Intégration de digital skills et intelligence artificielle
Semestre 3
-
Statistiques descriptives et analyse de données
-
Pétrographie / Minéralogie
-
Chimie minérale 1
-
Géomatique
-
Paleoenvironnement et stratigraphie
-
Langues et techniques de communication (Anglais 2)
-
Droit, civisme et citoyenneté
Semestre 4
-
Physiologie animale / Physiologie végétale
-
Biologie moléculaire et génétique
-
Analyse de données
-
Biochimie métabolique et enzymologie
-
Méthodes d'analyse chimique et biologique
-
Langues et techniques de communication (Français 2)
-
Développement personnel
Semestre 5
-
Physiologie des grandes fonctions
-
Physiologie microbienne / Microbiologie médicale
-
Neuroscience et développement du système nerveux
-
Biotechnologie / Biostatistique
-
Neuroendocrinologie
-
Immunologie / Hématologie
-
Algorithmique et programmation en Python
Semestre 6
-
Maladies neurodégénératives, métaboliques et cancéreuses
-
Pharmacologie / Qualité aux laboratoires de biologie médicale / Pharmacologie
-
Toxicologie
-
Entrepreneuriat et Management de Projet
-
Projet de fin d'études
Objectif de la formation
La filière Génie Biomédicale et Santé est une filière des sciences de la vie ayant un caractère professionnel à tendance biomédicale. Elle permet de former des techniciens spécialisés dans ce domaine. Elle se veut un point de rencontre entre les milieux professionnels et le monde universitaire.
La formation est orientée vers l’acquisition des avancées conceptuelles et technologiques les plus récentes de la biologie appliquée au domaine biomédical, notamment en ce qui concerne les méthodes analytiques et celles d’investigation. La finalité de ce cursus est de former des cadres spécialisés dans le domaine biomédical, notamment par l’acquisition des techniques d’analyses. Cette maîtrise du savoir faire dans ce domaine permettra sur un autre registre aux lauréats de se lancer dans le domaine de vente et de conseil, du matériel biomédical (expérience obtenue par l’utilisation de différents types de matériel lors des travaux pratiques). La création d’entités commerciales à petite échelle dans le domaine du paramédical et de la parapharmacie est également envisageable.
La licence Sciences et Techniques « Sciences Biologiques Appliquées » permet également aux lauréats de poursuivre des études de Master.
Conditions d'accès
Admission au semestre 1
-
Accès ouvert aux bacheliers scientifiques: Sciences de la Vie et de la Terre, Sciences Mathématiques, Sciences Physiques.
Admission au semestre 5
-
DEUST plus sélection après l'étude du dossier (dans la limite des places disponibles).
Débouchés et retombé de la formation
Les lauréats de la licence Génie Biomédicale et Santé acquièrent un niveau nécessaire et suffisant pour répondre aux exigences professionnelles dans le domaine de la santé. Ils peuvent ainsi être insérés dans le domaine de la santé tels que :
-
Laboratoires des analyses médicales;
-
Industrie pharmaceutique;
-
Laboratoires de contrôles au niveau des industries agro-alimentaires;
-
Développement de projets privés (PME-PMI) dans le domaine du paramédical et de la parapharmacie.
